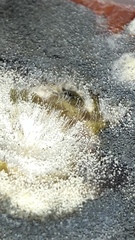
Botrytis cinerea
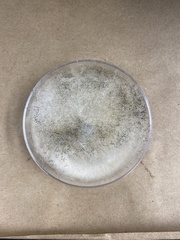
Botrytis cinerea
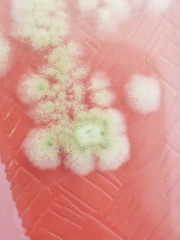
Botrytis cinerea
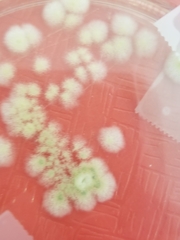
Botrytis cinerea
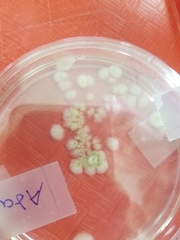
Botrytis cinerea

Botrytis cinerea: taxon details and analytics
- Domain
- Kingdom
- Fungi
- Phylum
- Ascomycota
- Class
- Leotiomycetes
- Order
- Helotiales
- Family
- Sclerotiniaceae
- Genus
- Botrytis
- Species
- Botrytis cinerea
- Scientific Name
- Botrytis cinerea
Summary description from Wikipedia:
Botrytis cinerea
Botrytis cinerea is a necrotrophic fungus that affects many plant species, including wine grapes. In viticulture, it is commonly known as "botrytis bunch rot"; in horticulture, it is usually called "grey mould" or "gray mold".
The fungus gives rise to two different kinds of infections on grapes. The first, grey rot, is the result of consistently wet or humid conditions, and typically results in the loss of the affected bunches. The second, noble rot, occurs when drier conditions follow wetter, and can result in distinctive sweet dessert wines, such as Sauternes, the Aszú of Tokaji, or Grasă de Cotnari. The species name Botrytis cinerea is derived from the Latin for "grapes like ashes"; the "grapes" refers to the bunching of the fungal spores on their conidiophores, while "ashes" refers to the greyish colour of the spores en masse. The fungus is usually referred to by its anamorph (asexual form) name, because the sexual phase is rarely observed. The teleomorph (sexual form) is an ascomycete, Botryotinia fuckeliana, also known as Botryotinia cinerea (see taxonomy box).
...Botrytis cinerea in languages:
- Afrikaans
- Vaalvrot
- Afrikaans
- Botritisvrot
- Bokmål
- gråskimmel
- Chinese
- 灰色葡萄孢菌
- Czech
- plíseň šedá
- English
- grey fruit mould
- English
- Gray Fruit Mold
- French
- Moisissure Grise des Fruits
- German
- Grauschimmel
- Lithuanian
- Pilkasis kekeras
- Swedish
- vanligt gråmögel
Images from inaturalist.org observations:
We recommend you sign up for this excellent, free service.
Parent Taxon
Sibling Taxa
- Botryotinia calthae
- Botryotinia convoluta
- Botryotinia ficariae
- Botryotinia ranunculi
- Botrytis aclada
- Botrytis allii
- Botrytis anthophila
- Botrytis atrofumosa
- Botrytis aurantiaca
- Botrytis bifurcata
- Botrytis byssoidea
- Botrytis capsularum
- Botrytis cinerea
- Botrytis convallariae
- Botrytis densa
- Botrytis elliptica
- Botrytis epigaea
- Botrytis fabae
- Botrytis fuliginosa
- Botrytis galanthina
- Botrytis gladioli
- Botrytis gladiolorum
- Botrytis latebricola
- Botrytis minutula
- Botrytis paeoniae
- Botrytis pannosa
- Botrytis pellicula
- Botrytis porri
- Botrytis pseudocinerea
- Botrytis sphaerosperma
- Botrytis squamosa
- Botrytis tulipae
- Botrytis umbellata